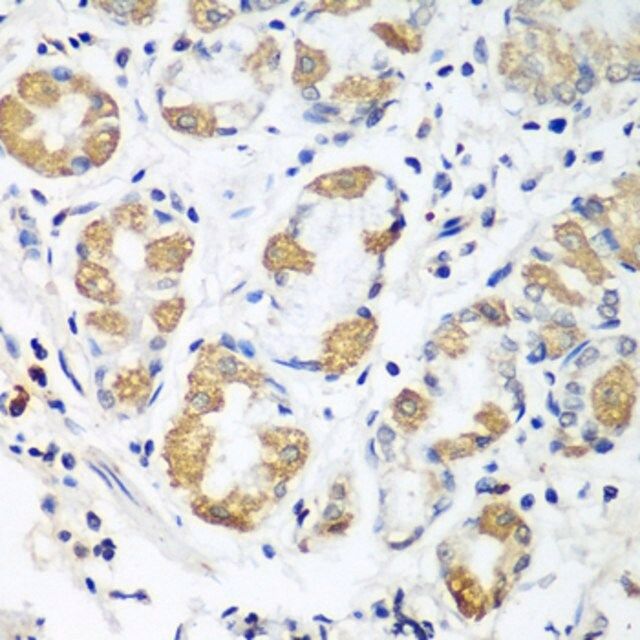

ФњЕФЮЛжУЃКЪзвГ > АыЕКbdЬхг§ЪжЛњПЭЛЇЖЫ
жааФ > Anti-OXCT1 antibody produced in rabbit
АыЕКbdЬхг§ЪжЛњПЭЛЇЖЫ
жааФ
Anti-OXCT1 antibody produced in rabbit

| АыЕКbdЬхг§ЪжЛњПЭЛЇЖЫ БрКХЃК | 4111754 |
| АќзАЙцИёЃК | 100 ІЬL |
| АыЕКbdЬхг§ЪжЛњПЭЛЇЖЫ РрБ№ЃК | НјПкЪдМС |
| ЦЗХЦЃК | Sigma-Aldrich |
| гХЛнМлЃК | СЂМДзЩбЏ |
АыЕКbdЬхг§ЪжЛњПЭЛЇЖЫ
МлИё
| АыЕКbdЬхг§ЪжЛњПЭЛЇЖЫ БрКХ | АќзАЕЅЮЛ | ЕЅМл(дЊ) | ЙњФкЯжЛѕ | ЙњЭтПтДц | бЏМлЕЅ |
| 4111754 | 100 ІЬL | 4710 |
АыЕКbdЬхг§ЪжЛњПЭЛЇЖЫ
Б№Ућ
Anti-OXCT1 antibody produced in rabbit
OXCT
OXCT1
SCOT
АыЕКbdЬхг§ЪжЛњПЭЛЇЖЫ
аджЪ
| biological sourceЁОЩњЮяРДдДЁП | rabbit |
| Quality LevelЁОжЪСПЫЎЦНЁП | 100 |
| antibody formЁОПЙЬхаЮЪНЁП | affinity isolated antibody |
| antibody product type | primary antibodies |
| cloneЁОПЫТЁЁП | polyclonal |
| formЁОаЮЪНЁП | buffered aqueous solution |
| mol wtЁОЗжзгСПЁП | 13 56 |
| species reactivity | rat, human, mouse |
| concentrationЁОХЈЖШЁП | 3.7 mg/ml |
| technique(s) | immunohistochemistry: 1:50-1:100 western blot: 1:500-1:2000 |
| UniProt accession no.ЁОUniProtЕЧМЧКХЁП | P55809 |
| shipped inЁОдЫЪфЁП | wet ice |
| storage temp.ЁОДЂДцЮТЖШЁП | −20Ёц |
| Gene Information | human ... OXCT1(5019) |
ЛљБОаХЯЂ
| General descriptionЁОвЛАуУшЪіЁП | This gene encodes a member of the 3-oxoacid CoA-transferase gene family. The encoded protein is a homodimeric mitochondrial matrix enzyme that plays a central role in extrahepatic ketone body catabolism by catalyzing the reversible transfer of coenzyme A from succinyl-CoA to acetoacetate. Mutations in this gene are associated with succinyl CoA:3-oxoacid CoA transferase deficiency. |
| ImmunogenЁОУтвпдЁП | Recombinant fusion protein containing a sequence corresponding to amino acids 261-520 of human OXCT1 (NP_000427.1). |
| Physical formЁОЭтаЮЁП | PBS with 0.02% sodium azide,50% glycerol,pH7.3. |
АыЕКbdЬхг§ЪжЛњПЭЛЇЖЫ
ЫЕУї
| Storage and StabilityЁОДЂДцМАЮШЖЈадЁП | Store at -20Ёц. Avoid freeze / thaw cycles. |
АВШЋаХЯЂ
| Storage Class CodeЁОДЂДцЗжРрДњТыЁП | 12 - Non Combustible Liquids |
| WGK | WGK 1 |